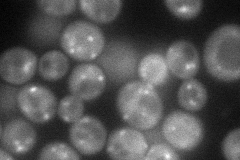
YMR275C
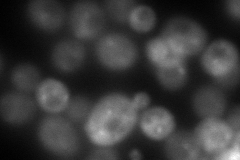
YMR275C
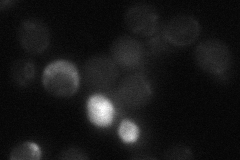
YMR275C
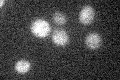
YMR275C

View description
Ubiquitin-binding component of the Rsp5p E3-ubiquitin ligase complex, functional homolog of Bul2p, disruption causes temperature-sensitive growth, overexpression causes missorting of amino acid permeases
Localization:
Intensity:
Fold change:
Significance:
-
C’ GFP library in SD

cytosol24.13 -
N' NOP1pr-GFP in SD
cytosol,punctate71.0009 -
N' TEF2pr-mCherry in SD
cytosol,punctateN/A -
N' NATIVEpr-GFP in SD
below threshold20.6262 -
N' TEF2pr-VC and Cyto-VN in SD

cytosol40.5575 -
C’ GFP library in SD+DTT

cytosol24.981.03No -
C’ GFP library in SD+H2O2

cytosol17.720.73No -
C’ GFP library in Starvation Media
cytosol18.350.76No -
C’ GFP library on the background of Pup2-DaMP

cytosol -
C’ GFP library on the background of CCT mutant

cytosol28.93421.19883No
